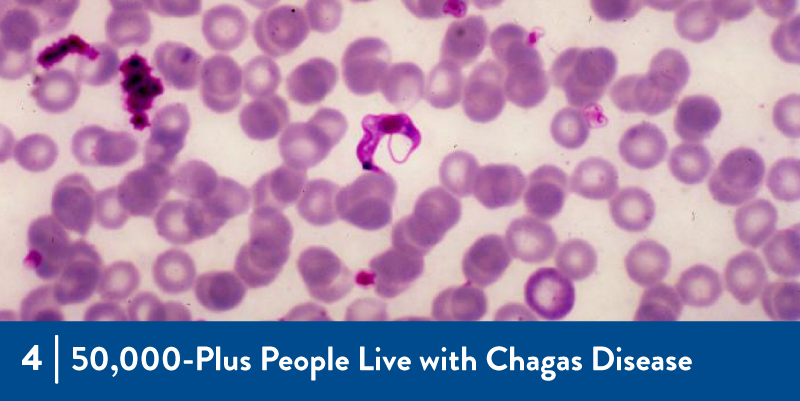
4 - 50,000-Plus People Live with Chagas Disease An image of the parasite responsible for Chagas Disease

Five on Friday: Title 42 Border Restrictions to Be Lifted

April is here! Spring is in full swing in many parts of the country, and not so much in other parts. At MCN offices this week, we've had snow flurries, pollen-laden winds, and tropical heat. Whatever your spring weather, why not start your weekend with Five on Friday? Every Friday, MCN staff shares their favorites to keep you up to date on migrant and immigrant health, justice, and disparities. Have a read and let us know what you think.
Getting questions about the 50+ second booster? As the CDC shifts gears on their vaccination approach, individuals will need to assess their personal risk. Amy shared NPR's Morning Edition segment on the topic: Do I Really Need Another Booster? The Answer Depends on Age, Risk and Timing
![]()
Kaethe shared this in-depth report, noting “This Report is focused, comprehensive, and well documented. It is a sobering read...The recommendations encompass past, present, and future factors that must be accounted for to address the scale of inequities Black Americans face.” The State of Black America and COVID-19: A Two-Year Assessment
![]()
Cloé sent around this NPR segment, noting that the results are still preliminary: Evidence Grows That Vaccines Lower the Risk of Getting Long COVID
![]()
Laz offered non-COVID infectious disease updates in this Outbreak News Today article focused on Chagas, which is endemic in 21 Central and South American countries and also found in the West and Southwest of the US. Spain: 50,000-Plus People Live with Chagas Disease, According to ISGlobal Estimates
![]()
Weekly Win: Hoorah! The Biden Administration has signaled that it is going to finally end its reliance on Title 42, which uses the pandemic as an excuse to expel asylum seekers at the US-Mexico border. Biden Administration Moves Forward with Plans to Lift Title 42 Border Restrictions
![]()
Have a safe and healthy weekend!
Like what you see? Amplify our collective voice with a contribution.
Got some good news to share? Contact us on our social media pages above.
Return to the main blog page or sign up for blog updates here.
- Log in to post comments